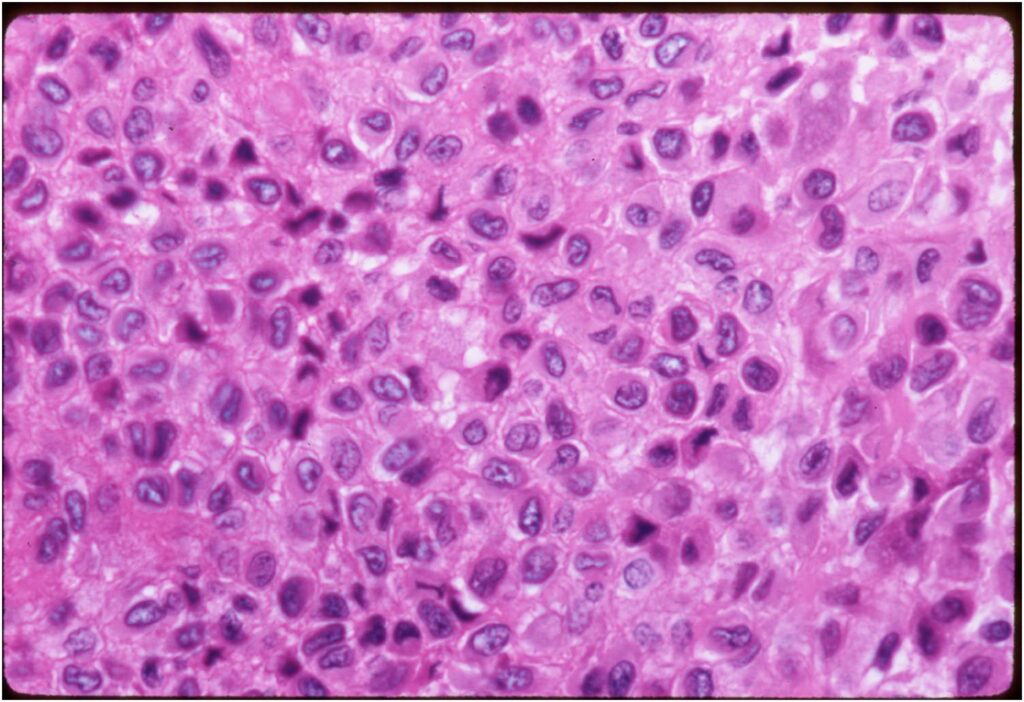

General Information
Codman Tumor (old historical name for chondroblastoma)
- Cartilage Containing Giant Cell Tumor (Kolodney 1972)
- Calcifying Giant Cell Tumor (Ewing 1928)
Clinical Data
- Rare; 1-2% all bone tumors
- Male predilection (2:1)
- Children and young adults; 90% 5-25 yrs. old
Benign aggresive tumor with high propensity for local recurrence
Very rare cases that metastasize to lungs
Location: almost all cases arise from epiphysis of bone
- Epiphysis/apophysis only 40% of cases
- Epiphysis and metaphysis 55% of cases
- Metaphysis only 4%
Differential diagnosis of epiphyseal lesions
- Chondroblastoma
- Clear cell chondrosarcoma
- Giant Cell Tumor (GCT)
- Subchondral Cyst/Intraosseous Ganglion
- Infection
- Eosinophilic Granuloma (LCH)
- Osteoid Osteoma
- Osteoblastoma
- Mets, myeloma, lymphoma
Clinical Presentation
Signs/Symptoms:
- Mild Pain lasting from months to several years
- 33% of patients have a joint effusion and swelling with limitations in range of motion
- Often confused with a sports injury
Prevalence:
- Male > Female 1.4:1
Age:
- Range 3-72 years
- 95% of cases occur between the ages 5 and 25
- Most cases occur in adolescents between 10 and 20 years of age
Sites:
- Predilection for distal femur, proximal tibia & humerus
- 98% located in epiphysis, 30% in knee area
- May also occur in calcaneus, talus and temporal bone
Most common locations:
- Proximal Femur 23%
- Distal Femur 20%
- Head and Neck 16%
- Trochanter 7%
- Proximal Tibia 17%
- Proximal Humerus 17%
- Hands and Feet 10%
Radiographic Presentation
- Presents as a highly defined/well circumscribed geographic oval/round lytic defect
- Surrounded by rim of sclerotic bone
- Usually in epiphyseal region
- Lesion ranges from 3 cm to 6 cm diameter
- Usually radiolucent
- May have fine trabeculae and irregular calcifications
- Calcifications are often better detected with a CT scan but are not uniformly present
- Lesions may expand the bone and new periosteal bone may form
- Bony end plate, cortex, bone contour are unaffected
Plain x-ray appearance:
- Geographic lytic lesion IA/IB margin of sclerosis
- Usually Eccentric more often than Central in the bone
- Rarely expansile (rarely penetrates the cortex)
- Calcified chondroid matrix 30%-50% of cases
- Often better detected with a CT Scan
- Periosteal Reaction 30-50% of cases
- Usually occurs in Adjacent Diaphysis/Metaphysis since epiphysis is intraarticular and not surrounded by periosteum
MRI appearance:
- Geographic, well circumscribed lesion in the epiphysis
- Intermediate Signal on T1
- High signal on T2 mixed with low signal areas (low signal areas proposed to be secondary to lysosomal content of highly cellular areas)
- Fluid/Fluid levels demonstrated in tumors that have undergone ABC change (aneurysmal bone cyst change)
- Extensive Surrounding edema is common
- Joint effusion in 30-50% of cases
CT appearance:
- Most useful for detecting subtle mineralization not apparent on X-rays
- Useful for identifying intact periosteum around any expansile soft tissue component
- surrounding thin reactive shell of bone/mineralization (Egg Shell Rim of Calcification)
- helps place the tumor in a benign category
- helps evaluate:
- bony quality
- extent of bone and cortical destruction
- whether the subchondral plate of bone adjacent to the articular cartilage has been destroyed or is intact
Bone scan: Chondroblastomas demonstrate intense increased uptake on a bone scan















Gross Pathology
- Grossly variable appearance
- Grey/yellow/brown and gritty if has interspersed calcifications
- Interspersed red areas from hemorrhagic necrosis
- May be blue-grey areas from the chondroid matrix
- Rim of sclerotic bone is visible in totally resected specimens
- Lesion may be fully cystic with solid foci of tumor tissue at periphery
- May undergo aneurysmal bone cyst change (ABC change)

Specimen: Curettings
Microscopic Pathology
- Variable appearance depending on percentage of cells, necrosis, cartilage matrix formation and ABC change
- Chondroid matrix in up to 15% of tumor
- ABC component 5-15% of tumors
- The tumor is composed of chondroblasts that have a distinct, thick cell membrane. The thick cell membrane gives it a “Chicken Wire Fence Appearance,” especially when the cell membranes are calcified

Biological Behavior
- benign aggressive tumors
- grow aggressively, destroy bone
- can destroy the cortex and grow into the soft tissues
- contained by the periosteum (this differs from a malignant tumor that destroys the cortex)
- EXTREMELY rare cases where chondroblastomas metastasize to the lungs after 30 years
- Metastases may remain stable or may progress and cause death
- Recurrences may occur in the bone or adjacent soft tissue
- Rare cases of multifocal chondroblastomas have been documented (Synchronous involvement of several sites)
- Secondary aneurysmal bone cyst frequently correlated with chondroblastoma
- Chondroblastomas have been reported to transform into fibrosarcoma or osteosarcoma years after being treated with radiation.
Treatment
- intralesional curettage resection and bone grafting most common treatment
- Cement and internal fixation may also be used to fill the defect after removal for selected patients
- High risk of local recurrence after curettage alone
- Local adjuvants such as cryosurgery (liquid nitrogen application) may be considered to decrease the risk of local recurrence
- Local recurrence results in further bony destruction
- Rarely, chondroblastomas that have grown out of control have required amputations because they have completely destroyed the bone and/or adjacent joint
- In patients who are skeletally immature (still growing) there is always a risk of growth plate failure from the chondroblastoma since it usually grows adjacent to the growth plate and may damage it
- CT Guided Radiofrequency Ablation (Minimally Invasive Approach)
- May be indicated for selected small tumors
- Mostly performed in specialized centers
- Treatment of a Chondroblastoma of Proximal Humerus with Intralesional Curettage Resection, Cryosurgery and Bone Grafting









Prognosis
- benign aggressive tumors that grow and destroy the bone and joint as it grows
- Most patients are cured with the first surgery
- significant risk of local recurrence (up to 30% with an intralesional curettage alone without an additional local adjuvant such as cryosurgery)
- Microscopic tumor cells can grow back after the tumor is removed
- My preferred method is to perform curettage and cryosurgery whenever feasible in appropriate cases in order to help eradicate microscopic disease and decrease the risk of local recurrence (decrease the risk of the tumor coming back in the bone after surgery)
- Radiofrequency has been successful in the treatment of very selected small tumors (minimally invasive approach)
- Rare cases of pulmonary metastases have been reported
- Pulmonary metastases may be stable or may progress and cause death
- Pulmonary metastases have extremely rarely been reported to develop 30 years after initial treatment